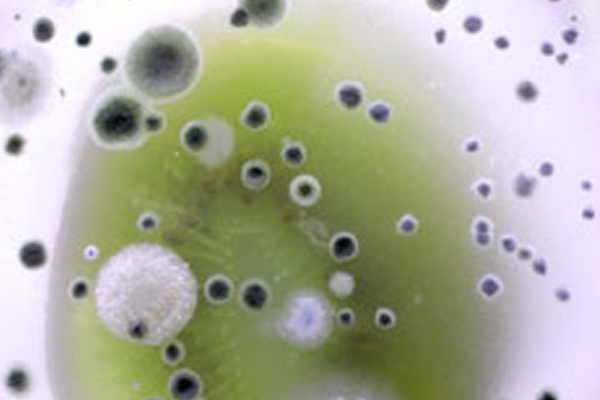
Lights

SRM 2310 – Multifunctional Scale Remover
Wimpey’s multifunctional scale remover uses an advanced chemical technologythat helps remove rust, corrosion, oxidation, heat and water scale from metal and concrete surfaces. It effectively penetrates water-wet, oil-wet deposits and willdissolve/disperse inorganic corrosion products of iron oxides, iron sulfides andpoly-sulfides as well as calcium and magnesium scales. This formula is non-hazardous without VOC content.